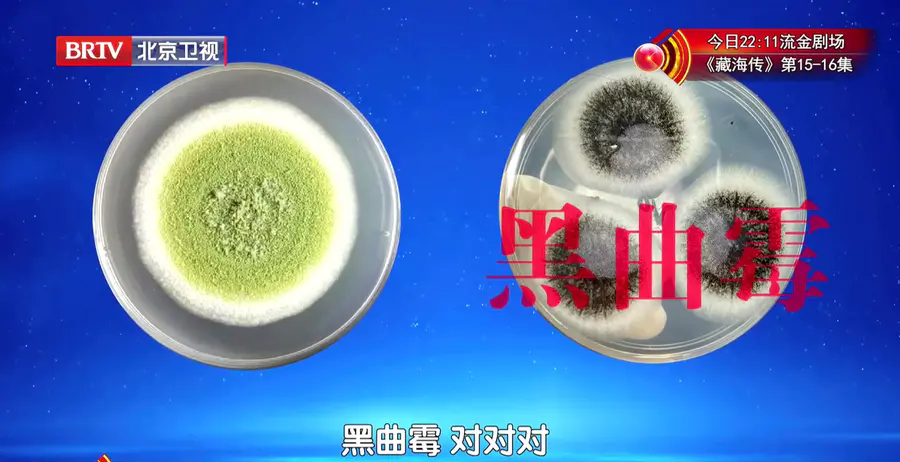

一种常见霉菌,是黑曲霉菌,它竟然和一类致癌物黄曲霉是同一家族

藏在我们家里环境中的霉菌,它会更隐秘、更不易察觉,同样会危害健康。

其中环境中的一种常见霉菌,是黑曲霉菌,它竟然和一类致癌物黄曲霉是同一家族。
黑曲霉菌落外表为圆形,呈黑色;

显微镜下放大后,黑曲霉有菌丝、孢子梗、孢子等结构,适宜温湿度下,孢子容易四处散落,继续繁殖成菌落。


一种常见霉菌,是黑曲霉菌,它竟然和一类致癌物黄曲霉是同一家族

藏在我们家里环境中的霉菌,它会更隐秘、更不易察觉,同样会危害健康。

其中环境中的一种常见霉菌,是黑曲霉菌,它竟然和一类致癌物黄曲霉是同一家族。
黑曲霉菌落外表为圆形,呈黑色;

显微镜下放大后,黑曲霉有菌丝、孢子梗、孢子等结构,适宜温湿度下,孢子容易四处散落,继续繁殖成菌落。


一种常见霉菌,是黑曲霉菌,它竟然和一类致癌物黄曲霉是同一家族

藏在我们家里环境中的霉菌,它会更隐秘、更不易察觉,同样会危害健康。

其中环境中的一种常见霉菌,是黑曲霉菌,它竟然和一类致癌物黄曲霉是同一家族。
黑曲霉菌落外表为圆形,呈黑色;
显微镜下放大后,黑曲霉有菌丝、孢子梗、孢子等结构,适宜温湿度下,孢子容易四处散落,继续繁殖成菌落。

关于北京时间|北京广播电视台&北京新媒体集团&北京网络广播电视台 版权所有|网上传播视听节目许可证0103028号|京ICP备17010175号-1|Copyright © 2026 Btime.com, All Rights Reserved
